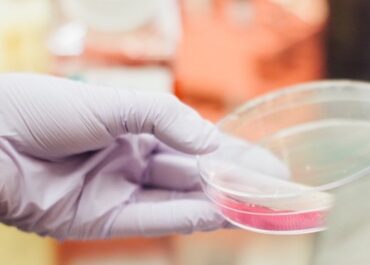

Распространённые вопросы о пластике уздечки полового члена
Распространённые вопросы о пластике уздечки полового члена Пластика уздечки полового члена – процедура, которая по-другому ещё называется френулектомия. Она подразумевает удлинение уздечки, и таким образом помогает избавиться от дискомфорта, который…Продовжити читання →